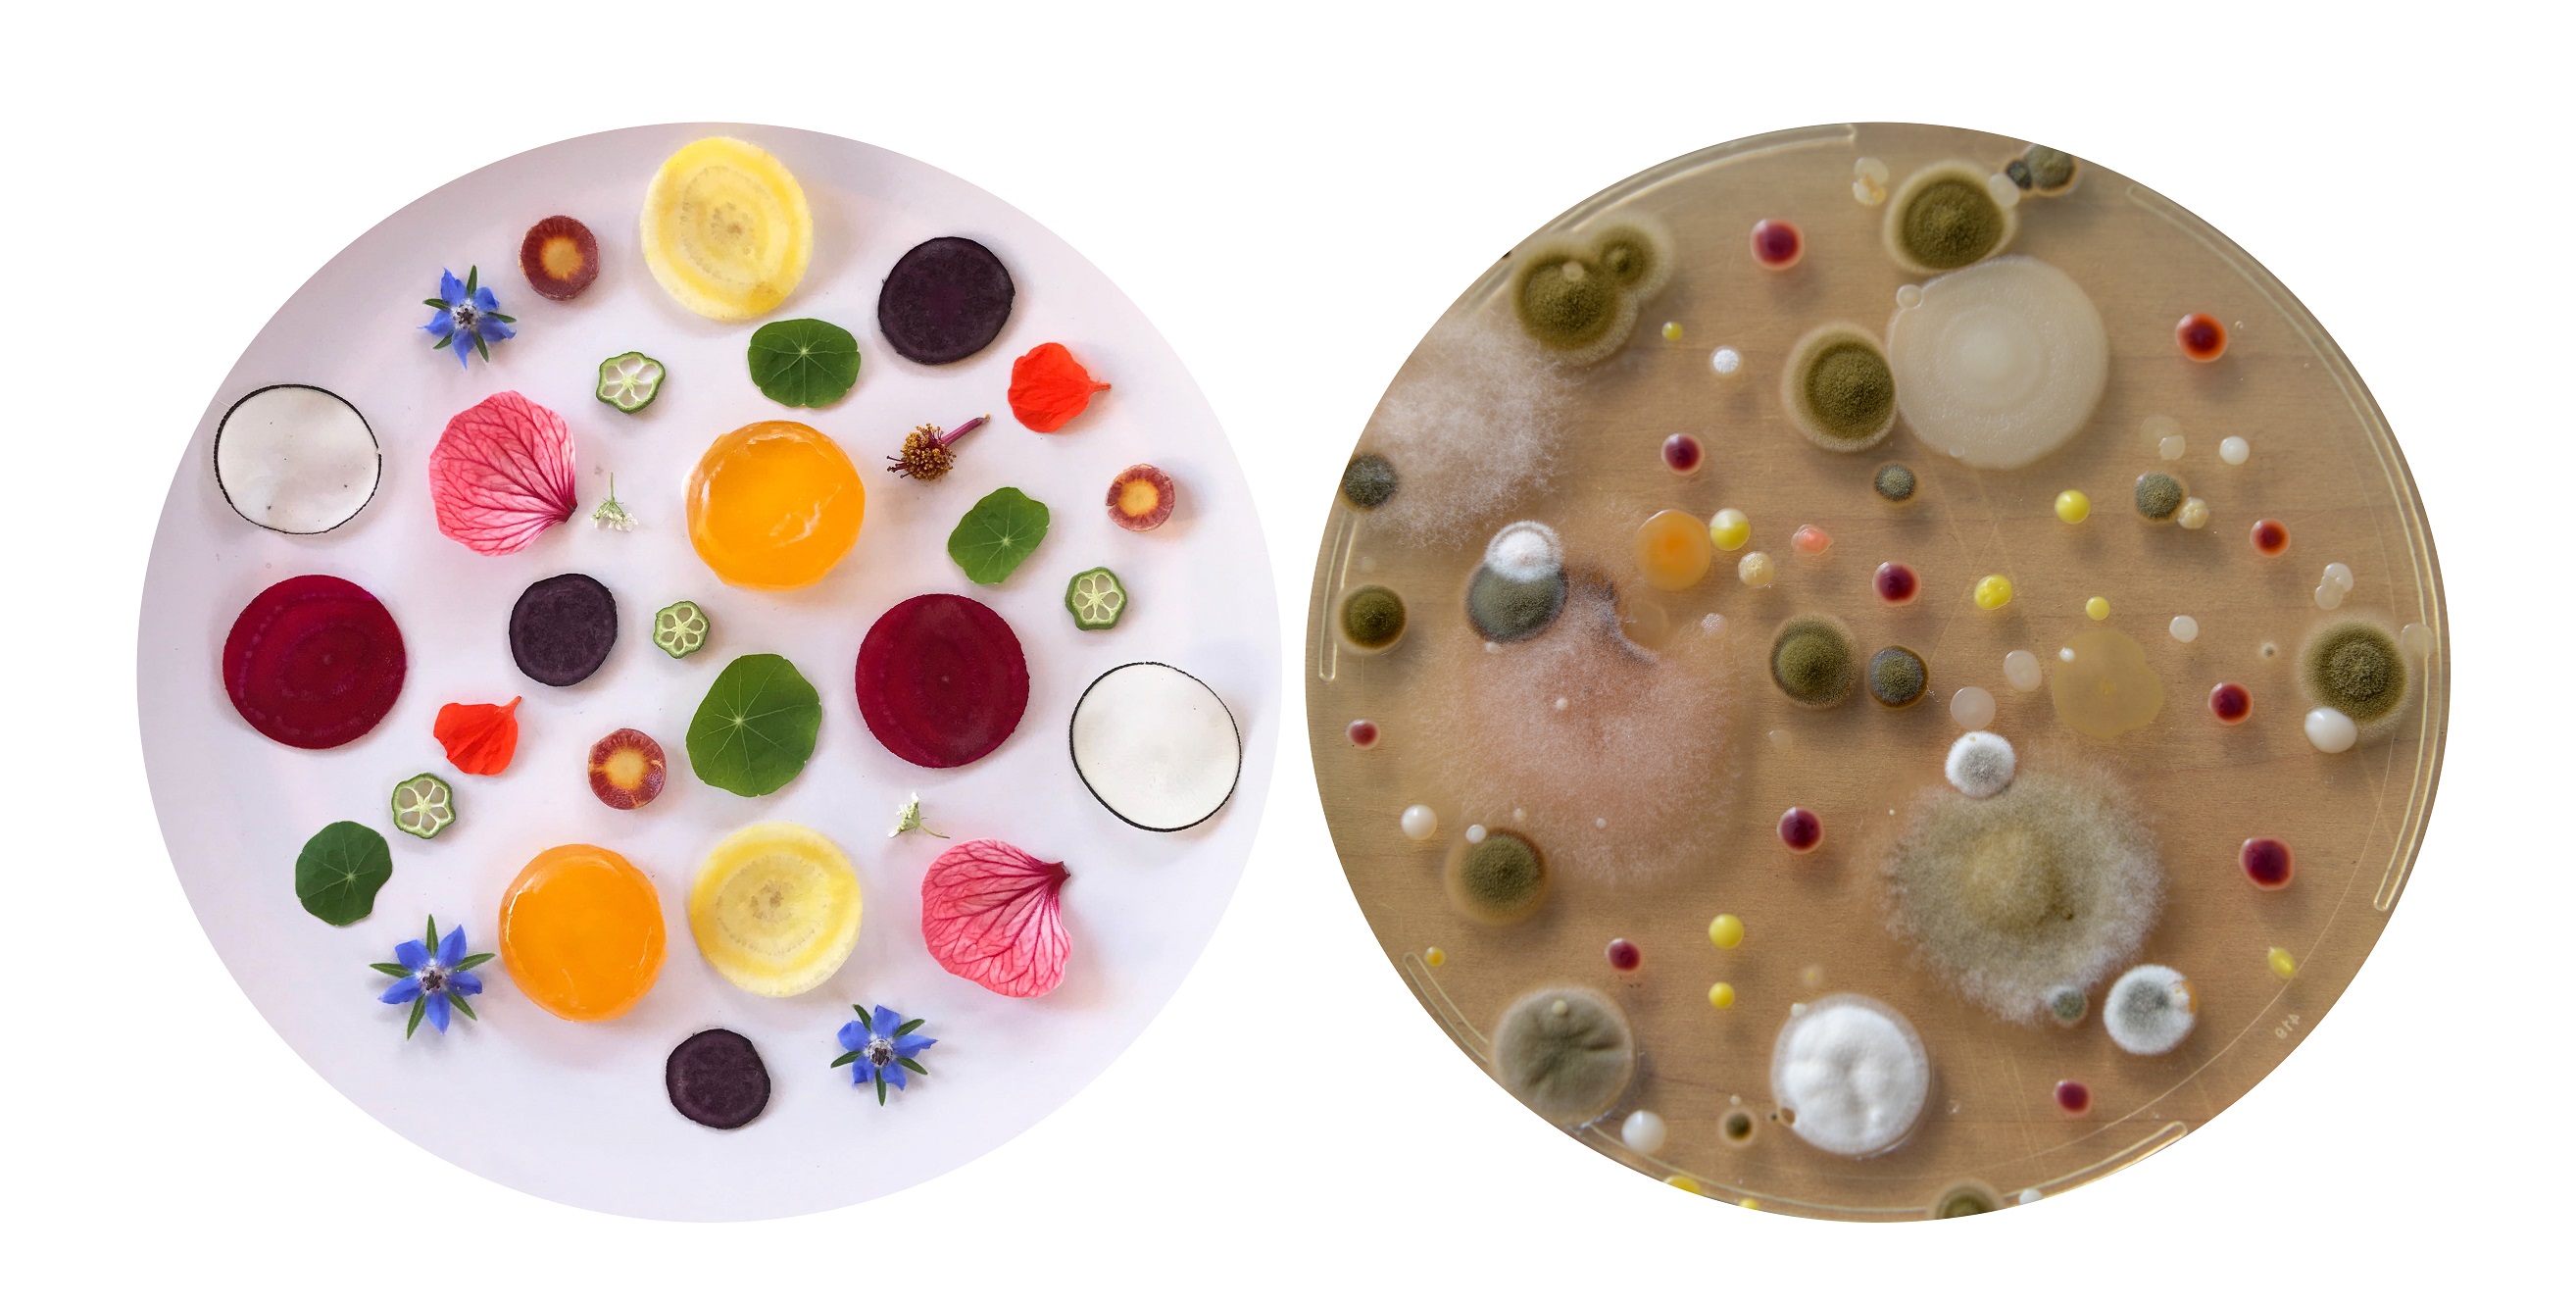
Helicobacter pylori a wrzody

Helicobacter pylori a wrzody
Co wywołuje wrzody żołądka?
Jeszcze 25 lat temu chorobę wrzodową wiązano głównie ze stresem i stylem życia. Obecnie wiadomo, że przyczyną ponad 90% wrzodów dwunastnicy, 60% - 80% wrzodów żołądka i większości przewlekłych nieżytów żołądka jest zakażenie bakteryjne, spowodowane obecnością bakterii Helicobacter pylori. Dużą rolę w rozprzestrzenianiu się drobnoustrojów przypisuje zakażeniom wewnątrzrodzinnym, gdzie najczęściej transmisja bakterii następuje między dorosłymi i dziećmi oraz między dziećmi. W 1994 roku Światowa Organizacja Zdrowia (WHO) przyjęła, że najgroźniejszym czynnikiem rakotwórczym żołądka i dwunastnicy jest właśnie Helicobacter pylori. Ocenia się, że zakażenie tą bakterią dotyczy ponad połowy populacji - 30% społeczeństwa krajów uprzemysłowionych i około 90% ludności krajów rozwijających się.
Co to jest Helicobacter pylori?
Helicobacter pylori jest groźną bakterią przewodu pokarmowego, często niesłusznie bagatelizowaną przez nas i długo niedającą objawów. Jednak to właśnie Helicobacter pylori uznaje się za głównego sprawcę powstawania nowotworu, zapaleń błony śluzowej żołądka i choroby wrzodowej układu pokarmowego. Jeszcze 20 lat temu schorzenia te łączono głównie ze stresem. Dzisiaj wiemy, że to właśnie bakteria Helicobacter pylori jest ich najczęstszym sprawcą.
Jak dochodzi do zakażenia bakterią H. pylori?
Wiadomo obecnie, że najczęściej do zakażenia tą bakterią dochodzi we wczesnym dzieciństwie i że jest ono bardzo powszechne. Bakterie chorobotwórcze obecne są w m.in. ślinie. Należy, zatem zwrócić szczególną uwagę na higienę życia codziennego, gdyż wykryto, że bakteria może być przenoszona np. z rodziców na dzieci poprzez używanie tych samych sztućców oraz picie ze wspólnych naczyń.
Jakie są objawy? Jak rozpoznać H. pylori?
Kiedy zaczynają nas męczyć typowe objawy - wymioty, bóle brzucha, wzdęcia, uczucie kwaśności w ustach, zwykle choroba jest już dość mocno rozwinięta i wymaga szybkiego działania terapeutycznego. Najpierw jednak warto wykonać gastroskopię żołądka, dzięki której z największą dokładnością lekarz może ocenić stan błony śluzowej żołądka. Podczas gastroskopii lekarz wprowadza przez przełyk giętki przewód zakończony minikamerą, przez którą ogląda błonę śluzową. Zwiększone dolegliwości z tytułu Helicobacter pylori są odczuwalne na wiosnę i na jesieni.
Jak pozbyć się tej bakterii? Czy konieczna jest w tym celu operacja?
Wrzody wywołane przez bakterię można wyleczyć bezoperacyjnie. Aby zniszczyć Helicobacter pylori, chorym przez tydzień podaje się dwa odpowiednio dobrane antybiotyki. Jednocześnie raz dziennie przyjmuje się tzw. inhibitor pompy protonowej - lek, który niemal do zera zmniejsza wydzielanie kwasu solnego. Aby kuracja była skuteczna, trzeba doprowadzić ją do końca. Błędem jest przerywanie jej, gdy tylko pacjent odczuje poprawę samopoczucia. Po zakończeniu terapii zaleca się stosowanie środków zmniejszających wydzielanie kwasu solnego i osłaniających śluzówkę żołądka.